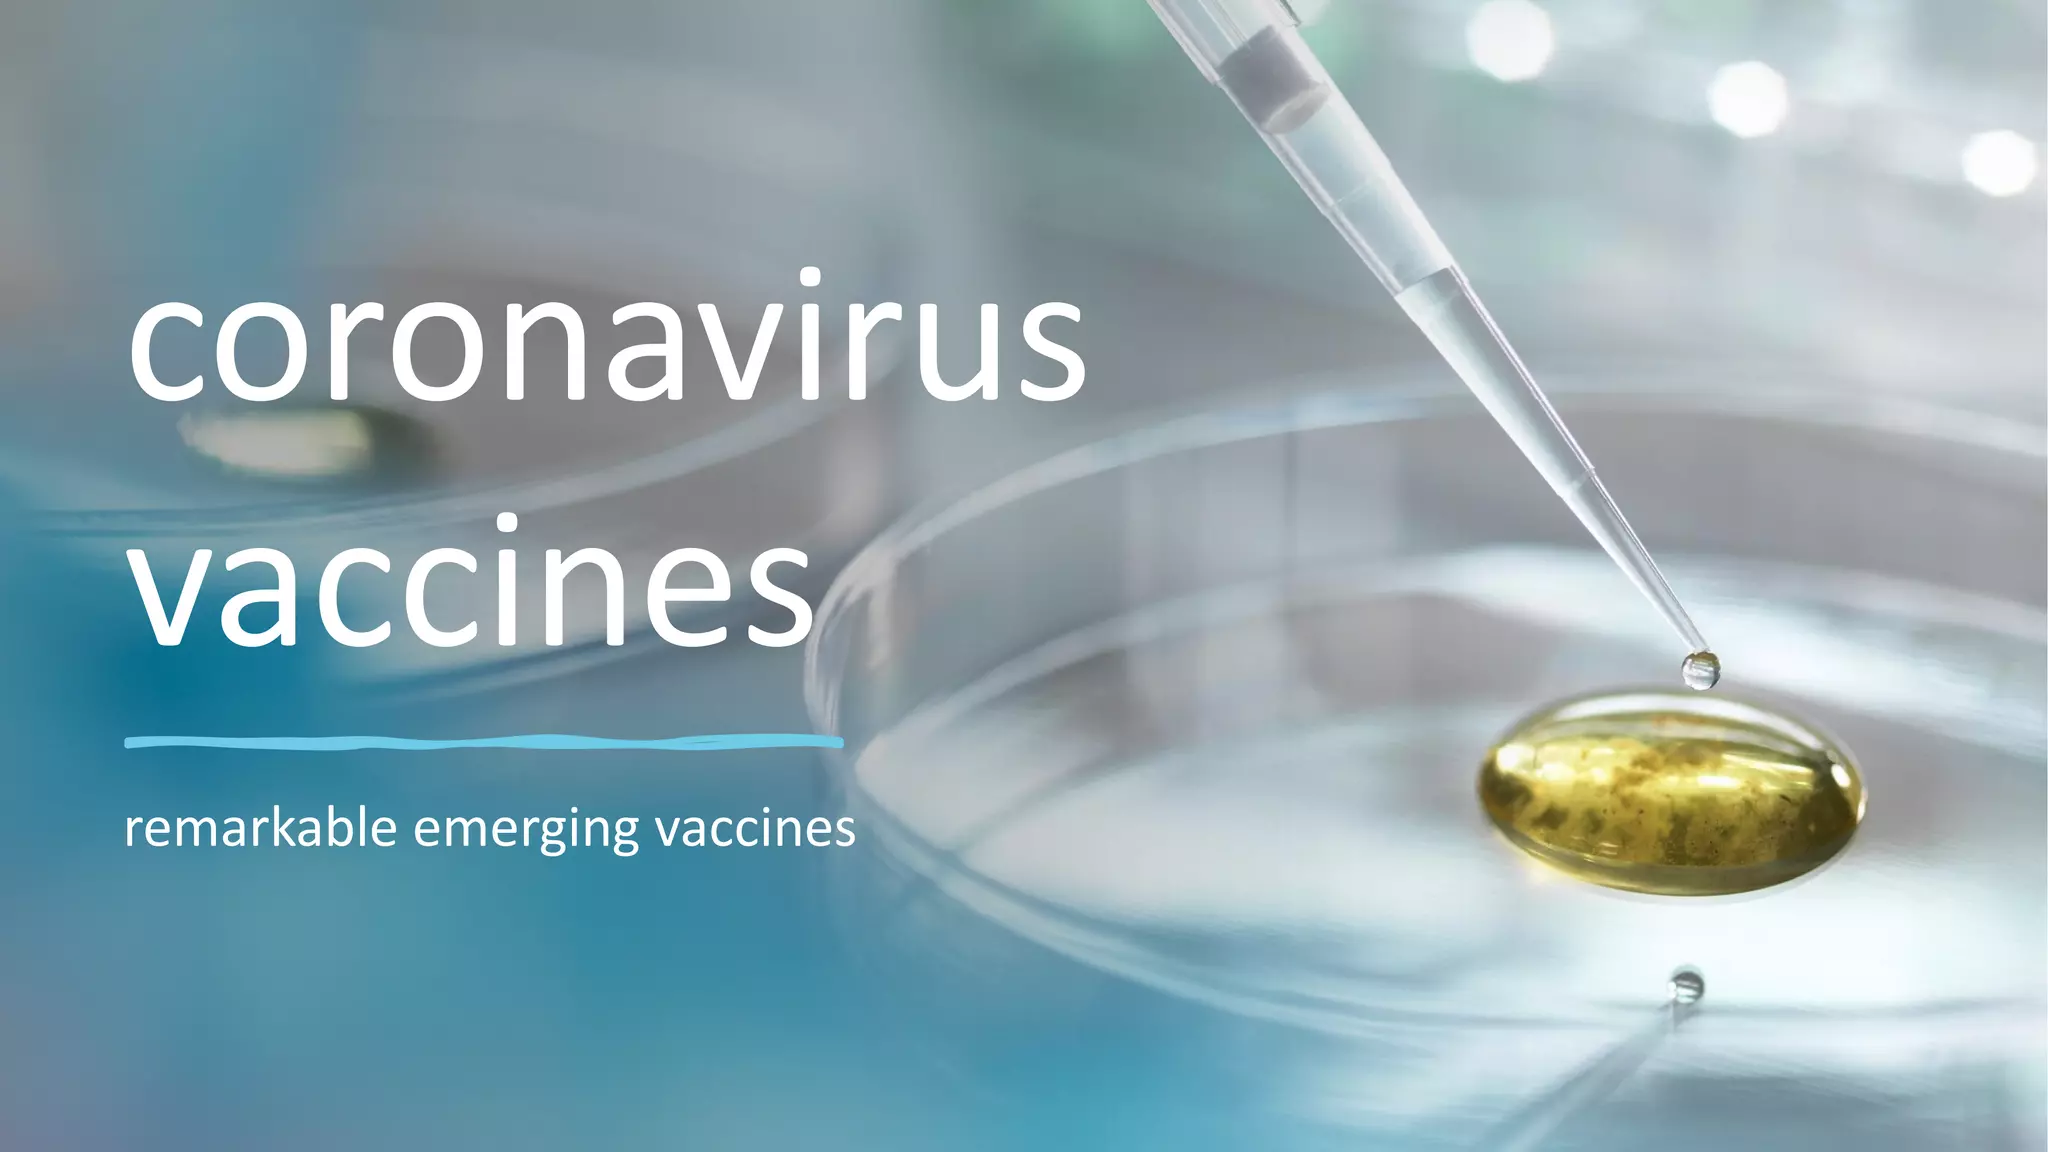

Coronaviruses are single-stranded RNA viruses that can cause respiratory infections in humans and other mammals. They derive their name from their crown-like appearance under microscopy. Several vaccines have been developed to provide immunity to COVID-19, including mRNA vaccines from Pfizer/BioNTech and Moderna, adenovirus vector vaccines from AstraZeneca/Oxford and Johnson & Johnson, and inactivated whole virus vaccines from Sinopharm and Bharat Biotech. These vaccines work by training the immune system to recognize the virus and produce antibodies to fight future infections.